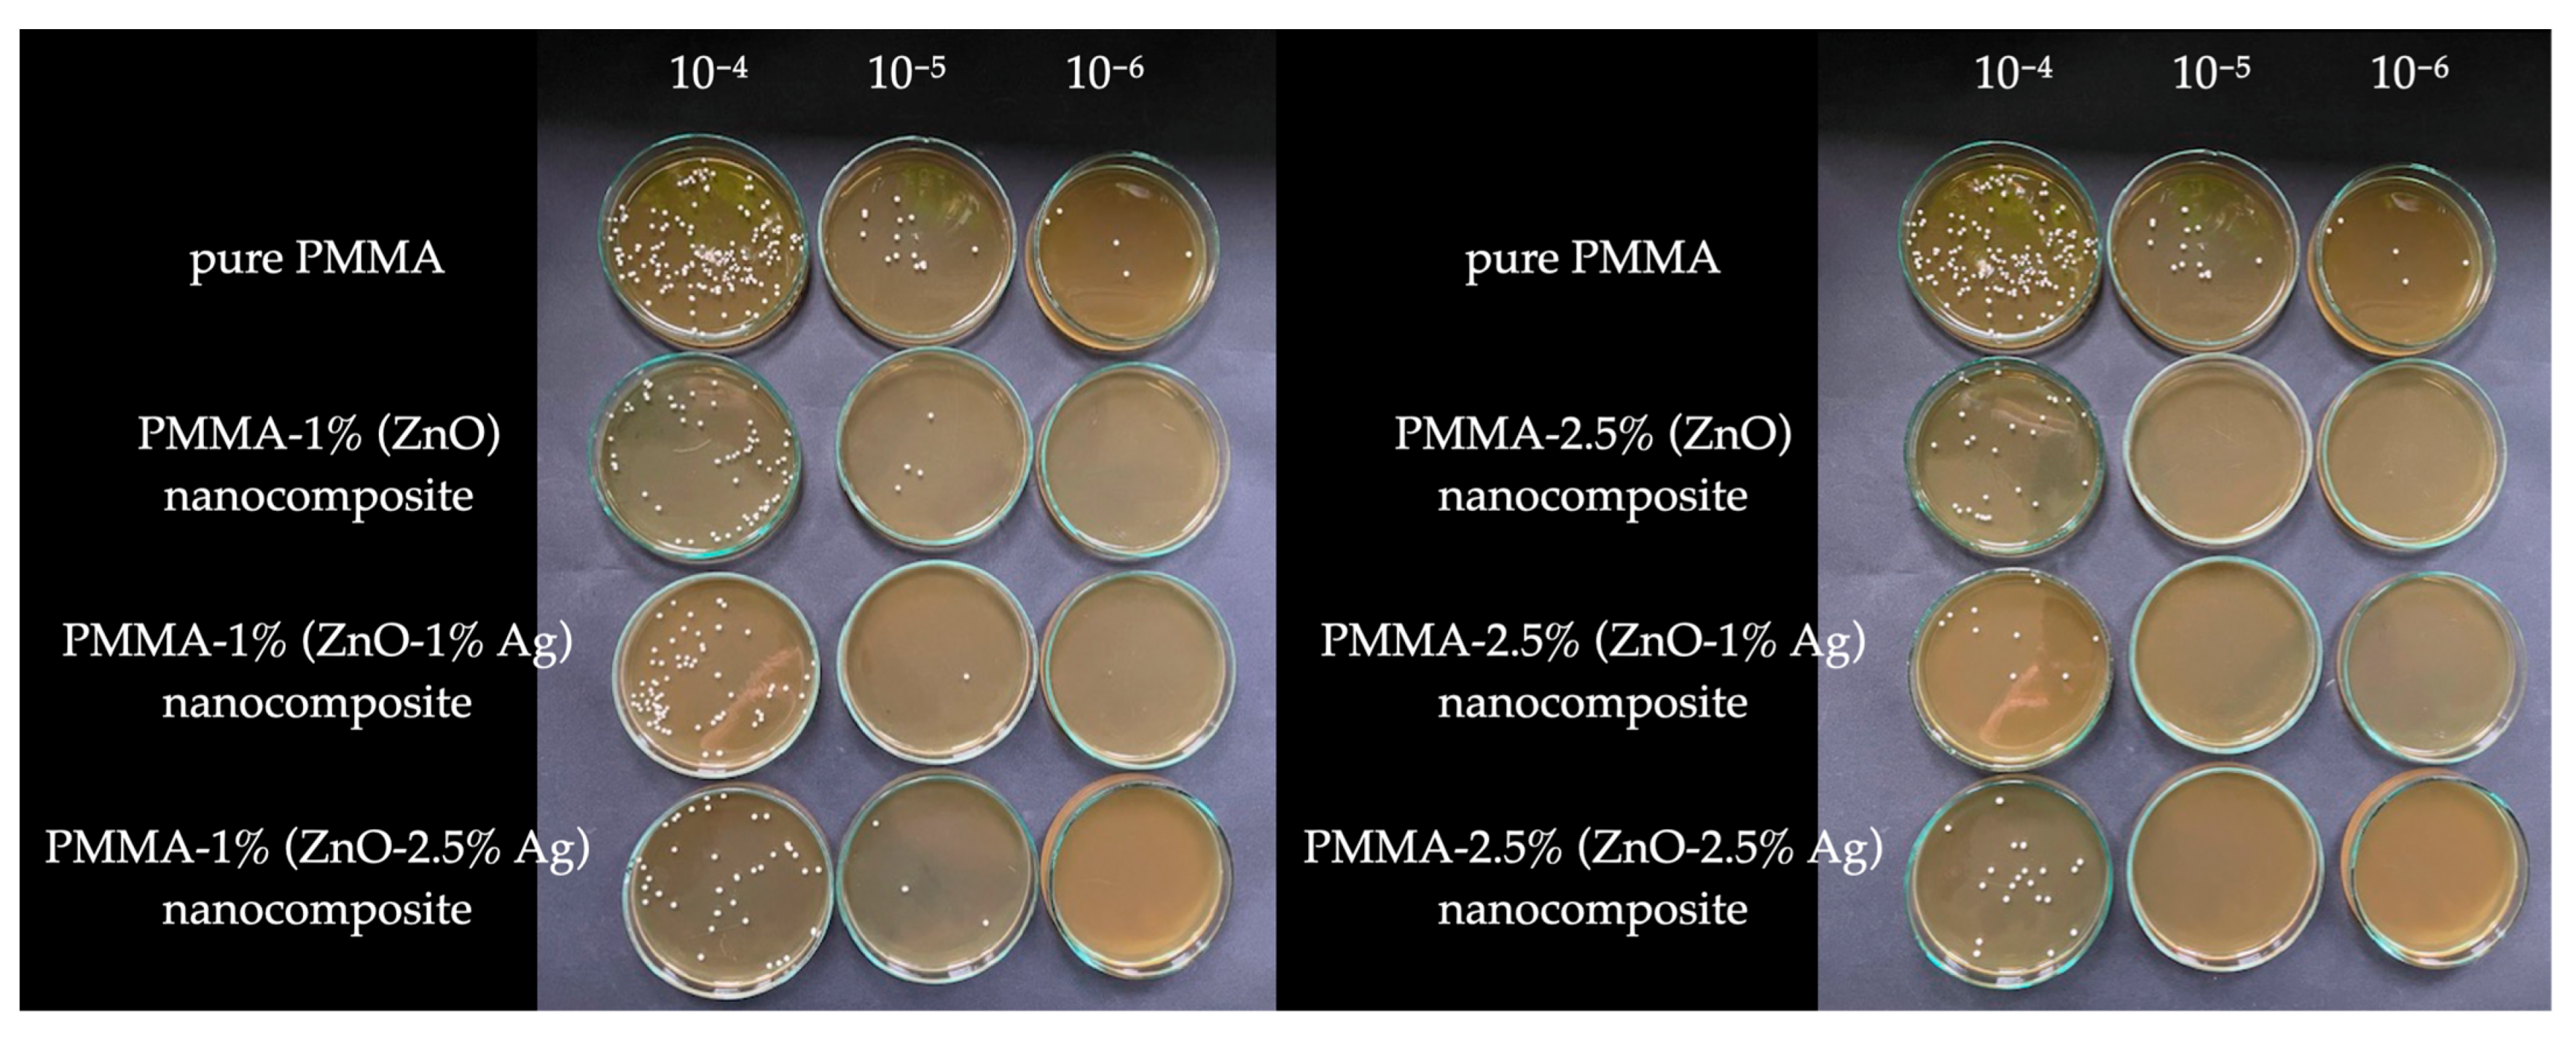
Polymers 16 03512 g005

Antifungal Activity of Newly Formed Polymethylmethacrylate (PMMA) Modification by Zinc Oxide and Zinc Oxide–Silver Hybrid Nanoparticles
Abstract
1. Introduction
2. Materials and Methods
2.1. Preparation and Characterization of Zinc Oxide and Silver Hybrid Nanoparticles
2.2. Preparation of Nanocomposite Samples
2.3. Examination of Minimum Inhibitory Concentration in Nanoparticles
2.4. Examination of Biofilm Formation
2.5. Influence of Nanocomposites on Candida albicans Solution
2.6. Biofilm Staining by Crystal Violet on Nanocomposites
3. Results
3.1. Characteristics of ZnO and Zno-Ag Nanoparticles
3.2. Minimal Inhibitory Concentration of ZnO and Zno-Ag Nanoparticle Solutions Against C. albicans
3.3. C. Albicans Biofilm Formed in the Presence of ZnO and Zno-Ag Nanoparticle Solutions
3.4. Influence of Acrylic-ZnO Nanocomposites Plates on Candida albicans Solution
3.5. Biofilm Staining with Crystal Violet of Acrylic Plates Containing ZnO and Zno-Ag
3.5.1. Crystal Violet Biofilm Staining of Acrylic: 1% (ZnO), 1% (ZnO-1% Ag), and 1% (ZnO-2.5% Ag) Plates
3.5.2. Crystal Violet Biofilm Staining of Acrylic: 2.5% (ZnO), 2.5% (ZnO-1% Ag), and 2.5% (ZnO-2.5% Ag) Plates
4. Discussion
5. Conclusions
Author Contributions
Funding
Institutional Review Board Statement
Data Availability Statement
Acknowledgments
Conflicts of Interest
References
- Kusama, T.; Aida, J.; Yamamoto, T.; Kondo, K.; Osaka, K. Infrequent Denture Cleaning Increased the Risk of Pneumonia among Community-dwelling Older Adults: A Population-based Cross-sectional Study. Sci. Rep. 2019, 9, 13734. [Google Scholar] [CrossRef] [PubMed]
- O’Donnell, L.E.; Smith, K.; Williams, C.; Nile, C.J.; Lappin, D.F.; Bradshaw, D.; Lambert, M.; Robertson, D.P.; Bagg, J.; Hannah, V.; et al. Dentures are a Reservoir for Respiratory Pathogens. J. Prosthodont. 2016, 25, 99–104. [Google Scholar] [CrossRef] [PubMed]
- Iinuma, T.; Arai, Y.; Abe, Y.; Takayama, M.; Fukumoto, M.; Fukui, Y.; Iwase, T.; Takebayashi, T.; Hirose, N.; Gionhaku, N.; et al. Denture wearing during sleep doubles the risk of pneumonia in the very elderly. J. Dent. Res. 2015, 94, 28s–36s. [Google Scholar] [CrossRef] [PubMed]
- Neppelenbroek, K.H. The importance of daily removal of the denture biofilm for oral and systemic diseases prevention. J. Appl. Oral. Sci. 2015, 23, 547–548. [Google Scholar] [CrossRef] [PubMed]
- Singh, S.; Palaskar, J.N.; Mittal, S. Comparative evaluation of surface porosities in conventional heat polymerized acrylic resin cured by water bath and microwave energy with microwavable acrylic resin cured by microwave energy. Contemp. Clin. Dent. 2013, 4, 147–151. [Google Scholar] [CrossRef]
- Pourhajibagher, M.; Bahador, A. Effects of incorporation of nanoparticles into dental acrylic resins on antimicrobial and physico-mechanical properties: A meta-analysis of in vitro studies. J. Oral. Biol. Craniofac. Res. 2022, 12, 557–568. [Google Scholar] [CrossRef]
- Jedynak, B.; Braksator, A. Professional hygiene procedures in patients wearing prosthetic restoration. Prosthodontics 2017, 67, 395–407. [Google Scholar]
- Obrąpalski, P.; Wieczorek, A. Methods of preventing biofilm deposition on removable dentures—Literature review. Prosthodontics 2021, 71, 279–288. [Google Scholar] [CrossRef]
- Mazur, M.W.; Wróbel-Bednarz, K.; Gawlak, D. Alternative methods of disinfection of removable prosthetic restorations—Microwaves, photodynamic therapy, electrolyzed water. Prosthodontics 2024, 74, 25–46. [Google Scholar] [CrossRef]
- Prażmo, E.J.; Mielczarek, A.B. Photodynamic therapy in the treatment of denture stomatitis. Prosthodontics 2017, 67, 355–363. [Google Scholar]
- Mierzwińska-Nastalska, E. Guidelines for the care and maintenance of complete dentures. Prosthodontics 2011, 61, 293–303. [Google Scholar]
- Walczak, M.; Walawska, A.; Wróbel-Bednarz, K. Combined pharmacological and prosthetic treatment of a patient presenting denture induced stomatitis complicated by fungal infection—Case report. Prosthodontics 2016, 66, 334–344. [Google Scholar] [CrossRef]
- Gad, M.M.; Fouda, S.M. Current perspectives and the future of Candida albicans-associated denture stomatitis treatment. Dent. Med. Probl. 2020, 57, 95–102. [Google Scholar] [CrossRef] [PubMed]
- Latib, Y.O.; Owen, C.P.; Patel, M. Viability of Candida albicans in Denture Base Resin After Disinfection: A Preliminary Study. Int. J. Prosthodont 2018, 31, 436–439. [Google Scholar] [CrossRef] [PubMed]
- Rao, S.; Nandish, B.T.; Ginjupalli, K.; Jayaprakash, K. A Review on Poly (Methyl Methacrylate) Denture Base Materials with Antimicrobial Properties. Trends Biomater. Artif. Organs 2021, 35, 316–322. [Google Scholar]
- Cierech, M.; Kolenda, A.; Grudniak, A.M.; Wojnarowicz, J.; Wozniak, B.; Golas, M.; Swoboda-Kopec, E.; Lojkowski, W.; Mierzwinska-Nastalska, E. Significance of polymethylmethacrylate (PMMA) modification by zinc oxide nanoparticles for fungal biofilm formation. Int. J. Pharm. 2016, 510, 323–335. [Google Scholar] [CrossRef]
- Strzelecka, K.; Szczesio-Włodarczyk, A.; Kopacz, K.; Kula, Z.M. Influence of nanosilver addition on the mechanical properties of acrylic material used for the manufacture of dental prostheses. Prosthodontics 2023, 73, 350–358. [Google Scholar] [CrossRef]
- Dębek, P.; Feliczak-Guzik, A.; Nowak, I. Nanostruktury—Ogólne informacje. Zastosowanie nanoobiektów w medycynie i kosmetologii. Nanostructures: General information. The use of nanoobjects in medicine and cosmetology. Adv. Hyg. Exp. Med. 2017, 71, 1055–1062. [Google Scholar] [CrossRef]
- Madkhali, O.A. A comprehensive review on potential applications of metallic nanoparticles as antifungal therapies to combat human fungal diseases. Saudi Pharm. J. 2023, 31, 101733. [Google Scholar] [CrossRef]
- Malik, S.; Muhammad, K.; Waheed, Y. Emerging Applications of Nanotechnology in Healthcare and Medicine. Molecules 2023, 28, 6624. [Google Scholar] [CrossRef]
- Pecci-Lloret, M.P.; Gea-Alcocer, S.; Murcia-Flores, L.; Rodriguez-Lozano, F.J.; Onate-Sanchez, R.E. Use of Nanoparticles in Regenerative Dentistry: A Systematic Review. Biomimetics 2024, 9, 243. [Google Scholar] [CrossRef] [PubMed]
- Meher, A.; Tandi, A.; Moharana, S.; Chakroborty, S.; Mohapatra, S.S.; Mondal, A.; Dey, S.; Chandra, P. Silver nanoparticle for biomedical applications: A review. Hybrid Adv. 2024, 6, 100184. [Google Scholar] [CrossRef]
- Robati Anaraki, M.; Jangjoo, A.; Alimoradi, F.; Maleki Dizaj, S.; Lotfipour, F. Comparison of Antifungal Properties of Acrylic Resin Reinforced with ZnO and Ag Nanoparticles. Pharm. Sci. 2017, 23, 207–214. [Google Scholar] [CrossRef]
- Wojnarowicz, J.; Chudoba, T.; Gierlotka, S.; Sobczak, K.; Lojkowski, W. Size Control of Cobalt-Doped ZnO Nanoparticles Obtained in Microwave Solvothermal Synthesis. Crystals 2018, 8, 179. [Google Scholar] [CrossRef]
- Wojnarowicz, J.; Opalinska, A.; Chudoba, T.; Gierlotka, S.; Mukhovskyi, R.; Pietrzykowska, E.; Sobczak, K.; Lojkowski, W. Effect of Water Content in Ethylene Glycol Solvent on the Size of ZnO Nanoparticles Prepared Using Microwave Solvothermal Synthesis. J. Nanomater. 2016, 2016, 2789871. [Google Scholar] [CrossRef]
- Wojnarowicz, J.; Chudoba, T.; Koltsov, I.; Gierlotka, S.; Dworakowska, S.; Lojkowski, W. Size control mechanism of ZnO nanoparticles obtained in microwave solvothermal synthesis. Nanotechnology 2018, 29, 065601. [Google Scholar] [CrossRef]
- Wojnarowicz, J.; Chudoba, T.; Gierlotka, S.; Lojkowski, W. Effect of Microwave Radiation Power on the Size of Aggregates of ZnO NPs Prepared Using Microwave Solvothermal Synthesis. Nanomaterials 2018, 8, 343. [Google Scholar] [CrossRef]
- Pokrowiecki, R.; Wojnarowicz, J.; Zareba, T.; Koltsov, I.; Lojkowski, W.; Tyski, S.; Mielczarek, A.; Zawadzki, P. Nanoparticles And Human Saliva: A Step Towards Drug Delivery Systems For Dental And Craniofacial Biomaterials. Int. J. Nanomed. 2019, 14, 9235–9257. [Google Scholar] [CrossRef]
- ISO Standard No. 9277:2010; Determination of the specific surface area of solids by gas adsorption—BET method, 2nd ed. International Organization for Standardization: Geneva, Switzerland, 2010.
- ISO Standard No. 12154:2014; Determination of density by volumetric displacement—Skeleton density by gas pycnometry, 1st ed. International Organization for Standardization: Geneva, Switzerland, 2014.
- Szałaj, U.; Świderska-Środa, A.; Chodara, A.; Gierlotka, S.; Łojkowski, W. Nanoparticle Size Effect on Water Vapour Adsorption by Hydroxyapatite. Nanomaterials 2019, 9, 1005. [Google Scholar] [CrossRef]
- European Committee for Antimicrobial Susceptibility Testing (EUCAST) of the European Society of Clinical Microbiology and Infectious Diseases (ESCMID). Determination of minimum inhibitory concentrations (MICs) of antibacterial agents by agar dilution. Clin. Microbiol. Infect. 2000, 6, 509–515. [Google Scholar] [CrossRef]
- Awad, M.A.; Hendi, A.A.; Ortashi, K.M.O.; Alanazi, A.B.; Alzahrani, B.A.; Soliman, D.A. Greener Synthesis, Characterization, and Antimicrobiological Effects of Helba Silver Nanoparticle-PMMA Nanocomposite. Int. J. Polym. Sci. 2019, 2019, 4379507. [Google Scholar] [CrossRef]
- Cierech, M.; Wojnarowicz, J.; Kolenda, A.; Łojkowski, W.; Mierzwińska-Nastalska, E.; Zawadzki, P. Characteristics of titanium nano-oxide (IV) as potent polymethyl metacrylate modifier. Prosthodontics 2017, 67, 4–17. [Google Scholar] [CrossRef]
- Cierech, M.; Osica, I.; Kolenda, A.; Wojnarowicz, J.; Szmigiel, D.; Łojkowski, W.; Kurzydłowski, K.; Ariga, K.; Mierzwińska-Nastalska, E. Mechanical and Physicochemical Properties of Newly Formed ZnO-PMMA Nanocomposites for Denture Bases. Nanomaterials 2018, 8, 305. [Google Scholar] [CrossRef] [PubMed]
- Chladek, G.; Mertas, A.; Barszczewska-Rybarek, I.; Nalewajek, T.; Zmudzki, J.; Król, W.; Lukaszczyk, J. Antifungal activity of denture soft lining material modified by silver nanoparticles-a pilot study. Int. J. Mol. Sci. 2011, 12, 4735–4744. [Google Scholar] [CrossRef]
- Nam, K.Y.; Lee, C.H.; Lee, C.J. Antifungal and physical characteristics of modified denture base acrylic incorporated with silver nanoparticles. Gerodontology 2012, 29, e413–e419. [Google Scholar] [CrossRef]
- Sun, J.; Wang, L.; Wang, J.; Li, Y.; Zhou, X.; Guo, X.; Zhang, T.; Guo, H. Characterization and evaluation of a novel silver nanoparticles-loaded polymethyl methacrylate denture base: In vitro and in vivo animal study. Dent. Mater. J. 2021, 40, 1100–1108. [Google Scholar] [CrossRef]
- Sokołowski, K.; Szynkowska, M.I.; Pawlaczyk, A.; Łukomska-Szymańska, M.; Sokołowski, J. The impact of nanosilver addition on element ions release form light-cured dental composite and compomer into 0.9% NaCl. Acta Biochim. Pol. 2014, 61, 317–323. [Google Scholar] [CrossRef]
- Cierech, M.; Szerszeń, M.; Wojnarowicz, J.; Łojkowski, W.; Kostrzewa-Janicka, J.; Mierzwińska-Nastalska, E. Colorimetric study of zinc oxide poly(methyl methacrylate) nanocomposite—New biomaterial for denture bases. Prosthodontics 2020, 70, 335–351. [Google Scholar] [CrossRef]
- Szerszeń, M.; Cierech, M.; Wojnarowicz, J.; Górski, B.; Mierzwińska-Nastalska, E. Color Stability of Zinc Oxide Poly(methyl methacrylate) Nanocomposite—A New Biomaterial for Denture Bases. Polymers 2022, 14, 4982. [Google Scholar] [CrossRef]
- Yadav, S.; Kumar, N.; Mari, B.; Mittal, A.; Jangra, V.; Sharma, A.; Kumari, K. Ag/ZnO nano-structures synthesized by single-step solution combustion approach for the photodegradation of Cibacron Red and Triclopyr. Appl. Nanosci. 2021, 11, 1977–1991. [Google Scholar] [CrossRef]
- Zhu, X.; Wang, J.; Yang, D.; Liu, J.; He, L.; Tang, M.; Feng, W.; Wu, X. Fabrication, characterization and high photocatalytic activity of Ag-ZnO heterojunctions under UV-visible light. RSC Adv. 2021, 11, 27257–27266. [Google Scholar] [CrossRef] [PubMed]
- Thatikayala, D.; Banothu, V.; Kim, J.; Shin, D.S.; Vijayalakshmi, S.; Park, J. Enhanced photocatalytic and antibacterial activity of ZnO/Ag nanostructure synthesized by Tamarindus indica pulp extract. J. Mater. Sci. Mater. Electron. 2020, 31, 5324–5335. [Google Scholar] [CrossRef]
- Busila, M.; Musat, V.; Alexandru, P.; Romanitan, C.; Brincoveanu, O.; Tucureanu, V.; Mihalache, I.; Iancu, A.-V.; Dediu, V. Antibacterial and Photocatalytic Activity of ZnO/Au and ZnO/Ag Nanocomposites. Int. J. Mol. Sci. 2023, 24, 16939. [Google Scholar] [CrossRef]
- Verma, A.; Kumar, N.; Agarwal, R.; Chauhan, S.; Jain, V.K.; Sengupta, S. Fabrication and evaluation of ZnO–Ag nanocomposites exhibiting enhanced antibacterial properties and their potential applications. React. Kinet. Mech. Catal. 2024, 137, 3037–3045. [Google Scholar] [CrossRef]
- Amrute, V.; Monika; Supin, K.K.; Vasundhara, M.; Chanda, A. Observation of excellent photocatalytic and antibacterial activity of Ag doped ZnO nanoparticles. RSC Adv. 2024, 14, 32786–32801. [Google Scholar] [CrossRef]
- Gondal, M.A.; Alzahrani, A.J.; Randhawa, M.A.; Siddiqui, M.N. Morphology and antifungal effect of nano-ZnO and nano-Pd-doped nano-ZnO against Aspergillus and Candida. J. Environ. Sci. Health A Tox Hazard. Subst. Environ. Eng. 2012, 47, 1413–1418. [Google Scholar] [CrossRef]
- Khan, M.F.; Hameedullah, M.; Ansari, A.H.; Ahmad, E.; Lohani, M.B.; Khan, R.H.; Alam, M.M.; Khan, W.; Husain, F.M.; Ahmad, I. Flower-shaped ZnO nanoparticles synthesized by a novel approach at near-room temperatures with antibacterial and antifungal properties. Int. J. Nanomed. 2014, 9, 853–864. [Google Scholar] [CrossRef]
- Ahamad, I.; Bano, F.; Anwer, R.; Srivastava, P.; Kumar, R.; Fatma, T. Antibiofilm Activities of Biogenic Silver Nanoparticles Against Candida albicans. Front. Microbiol. 2021, 12, 741493. [Google Scholar] [CrossRef]
- Longhi, C.; Santos, J.P.; Morey, A.T.; Marcato, P.D.; Durán, N.; Pinge-Filho, P.; Nakazato, G.; Yamada-Ogatta, S.F.; Yamauchi, L.M. Combination of fluconazole with silver nanoparticles produced by Fusarium oxysporum improves antifungal effect against planktonic cells and biofilm of drug-resistant Candida albicans. Med. Mycol. 2016, 54, 428–432. [Google Scholar] [CrossRef]
- Cierech, M.; Wojnarowicz, J.; Szmigiel, D.; Bączkowski, B.; Grudniak, A.M.; Wolska, K.I.; Łojkowski, W.; Mierzwińska-Nastalska, E. Preparation and characterization of ZnO-PMMA resin nanocomposites for denture bases. Acta Bioeng. Biomech. 2016, 18, 31–41. [Google Scholar]
- Chandra, J.; Kuhn, D.M.; Mukherjee, P.K.; Hoyer, L.L.; McCormick, T.; Ghannoum, M.A. Biofilm formation by the fungal pathogen Candida albicans: Development, architecture, and drug resistance. J. Bacteriol. 2001, 183, 5385–5394. [Google Scholar] [CrossRef]
- Takamiya, A.S.; Monteiro, D.R.; Gorup, L.F.; Silva, E.A.; de Camargo, E.R.; Gomes-Filho, J.E.; de Oliveira, S.H.P.; Barbosa, D.B. Biocompatible silver nanoparticles incorporated in acrylic resin for dental application inhibit Candida albicans biofilm. Mater. Sci. Eng. C Mater. Biol. Appl. 2021, 118, 111341. [Google Scholar] [CrossRef] [PubMed]
- Cierech, M.; Wojnarowicz, J.; Kolenda, A.; Krawczyk-Balska, A.; Prochwicz, E.; Woźniak, B.; Łojkowski, W.; Mierzwińska-Nastalska, E. Zinc Oxide Nanoparticles Cytotoxicity and Release from Newly Formed PMMA-ZnO Nanocomposites Designed for Denture Bases. Nanomaterials 2019, 9, 1318. [Google Scholar] [CrossRef] [PubMed]
- Hamidian, K.; Sarani, M.; Sheikhi, E.; Khatami, M. Cytotoxicity evaluation of green synthesized ZnO and Ag-doped ZnO nanoparticles on brain glioblastoma cells. J. Mol. Struct. 2022, 1251, 131962. [Google Scholar] [CrossRef]

| NPs Name | Specific Surface Area by Gas Adsorption, as ± σ (m2/g) | Total Pore Volume (cm3/g) | Skeleton Density by Gas Pycnometry, ρs ± σ (g/cm3) | Average Particle Size from SSA BET, d ± σ (nm) |
|---|---|---|---|---|
| ZnO-1% | 49.0 ± 0.1 | 0.283 | 5.079 ± 0.036 | 24 |
| ZnO-1% Ag | 46.6 ± 0.1 | 0.255 | 5.147 ± 0.019 | 25 |
| ZnO-2.5% Ag | 40.6 ± 0.1 | 0.280 | 5.158 ± 0.031 | 29 |
| Solution | MIC—mg/mL Candida albicans 14053 |
|---|---|
| ZnO-1% | 1 |
| ZnO-1% Ag | 0.5 |
| ZnO-2.5% Ag | 1 |
| 10−4 Dilution | 10−5 Dilution | 10−6 Dilution | |
|---|---|---|---|
| pure PMMA | 1.25 × 107 | 1.6 × 107 | 7 × 106 |
| PMMA-1% (ZnO) nanocomposite | 6.1 × 106 | 3 × 106 | 0 |
| PMMA-1% (ZnO-1% Ag) nanocomposite | 7.15 × 106 | 3 × 105 | 0 |
| PMMA-1% (ZnO-2.5% Ag) nanocomposite | 4.4 × 106 | 3.3 × 106 | 0 |
| PMMA-2.5% (ZnO) nanocomposite | 1.7 × 106 | 0 | 0 |
| PMMA-2.5% (ZnO-1% Ag) nanocomposite | 3 × 105 | 0 | 0 |
| PMMA-2.5% (ZnO-2.5% Ag) nanocomposite | 3 × 106 | 0 | 0 |
Disclaimer/Publisher’s Note: The statements, opinions and data contained in all publications are solely those of the individual author(s) and contributor(s) and not of MDPI and/or the editor(s). MDPI and/or the editor(s) disclaim responsibility for any injury to people or property resulting from any ideas, methods, instructions or products referred to in the content. |
© 2024 by the authors. Licensee MDPI, Basel, Switzerland. This article is an open access article distributed under the terms and conditions of the Creative Commons Attribution (CC BY) license (https://creativecommons.org/licenses/by/4.0/).
Share and Cite
Mazur, M.W.; Grudniak, A.; Szałaj, U.; Szerszeń, M.; Mizeracki, J.; Cierech, M.; Mierzwińska-Nastalska, E.; Kostrzewa-Janicka, J. Antifungal Activity of Newly Formed Polymethylmethacrylate (PMMA) Modification by Zinc Oxide and Zinc Oxide–Silver Hybrid Nanoparticles. Polymers 2024, 16, 3512. https://doi.org/10.3390/polym16243512
Mazur MW, Grudniak A, Szałaj U, Szerszeń M, Mizeracki J, Cierech M, Mierzwińska-Nastalska E, Kostrzewa-Janicka J. Antifungal Activity of Newly Formed Polymethylmethacrylate (PMMA) Modification by Zinc Oxide and Zinc Oxide–Silver Hybrid Nanoparticles. Polymers. 2024; 16(24):3512. https://doi.org/10.3390/polym16243512
Chicago/Turabian StyleMazur, Marek Witold, Anna Grudniak, Urszula Szałaj, Marcin Szerszeń, Jan Mizeracki, Mariusz Cierech, Elżbieta Mierzwińska-Nastalska, and Jolanta Kostrzewa-Janicka. 2024. "Antifungal Activity of Newly Formed Polymethylmethacrylate (PMMA) Modification by Zinc Oxide and Zinc Oxide–Silver Hybrid Nanoparticles" Polymers 16, no. 24: 3512. https://doi.org/10.3390/polym16243512
APA StyleMazur, M. W., Grudniak, A., Szałaj, U., Szerszeń, M., Mizeracki, J., Cierech, M., Mierzwińska-Nastalska, E., & Kostrzewa-Janicka, J. (2024). Antifungal Activity of Newly Formed Polymethylmethacrylate (PMMA) Modification by Zinc Oxide and Zinc Oxide–Silver Hybrid Nanoparticles. Polymers, 16(24), 3512. https://doi.org/10.3390/polym16243512

